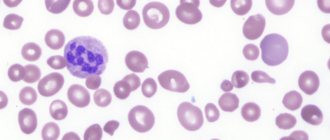

Железодефицитная анемия (ЖДА) — одно из наиболее часто диагностируемых патологических состояний кровеносной системы, да и вообще самый распространенный вид анемии.
Статистические исследования показали, что около 2,5 млрд. пациентов во всем мире имеют этот диагноз.
Для того чтобы остановить прогрессирование заболевания и избежать осложнений, необходимо выявить первопричины его появления и своевременно начать лечение.
Что такое железодефицитная анемия?
Анемия характеризуется пониженным содержанием в кровеносной системе человека красных кровяных телец — эритроцитов, и, как следствие, падением гемоглобина.
Если низкий уровень этих элементов связан с недостатком железа в организме, то в данном случае речь идет о железодефицитной анемии (ЖДА).
Как правило, патология не является самостоятельным заболеванием. В большинстве случаев железодефицитная анемия возникает вслед за какими-либо другими негативными изменениями в организме человека.
ДЛЯ СПРАВКИ! Норма содержания железа в организме у взрослых в среднем составляет около 4 грамм. У мужчин и женщин в разном возрасте этот показатель может иметь различное значение. Так, например, железодефицитная анемия у взрослых гораздо чаще проявляется у представительниц слабого пола. Прежде всего, это связано с регулярными потерями крови, происходящими во время менструаций. А наиболее сильная концентрация железа наблюдается у новорожденных младенцев, поскольку они имеют усиленную подпитку этим микроэлементом в утробе матери.
Дефицит железа плохо сказывается на жизнеспособности человека в целом. Кроме того, развитие этой недостаточности чревато сбоями в образовании эритроцитов, а также нарушением реакций окисления и восстановления, механизма деления клеток и нормального течения некоторых других реакций.
Железо является основой гемоглобина, выполняющего функции снабжения кислородом всех тканей и органов в теле человека, а также играющего важную роль в синтезе белка и гормонов. Если дефицит железа не восполняется в течение длительного времени, у пациента начинает развиваться анемический синдром.
Какие причины появления?
Так как дефицит железа в организме женщины наступает в следствии недостатка гемоглобина в крови, то и причины появления анемии непосредственно связанны с отклонением количественного показателя эритроцитов и белка гемоглобина.
Хронический гастрит
Причины, провоцирующие женское малокровие:
Соблюдение диет, с малым содержанием железа, неправильное питание.
Генетическая предрасположенность. Некоторые виды анемии передаются наследственно (серповидноклеточная).
Хронический гастрит. При поражении данным заболеванием происходит значительное снижение соляной кислоты.
Кишечные кровотечения. Один из самых трудно определяемых и неприятных факторов.
Они не выдают болевых ощущений в кишечнике, а лишь проявляются в изменении оттенка каловых масс. В большинстве случаев, на это не обращают внимания.
Отклонения в формировании белка гемоглобина, что приводит к значительному упадку количества эритроцитов.
Присутствие в организме плоских червей (гельмитонов), поражающих разные органы.
Обильные потери крови при травмах и открытых ранениях.
Нарушения желудочного тракта, в следствии чего нарушаются процессы всасывания железа.
Вынашивание ребенка. При беременности, происходит большее потребление организмом железа, так как им питается и сам плод. Именно поэтому, женщинам, которые вынашивают ребенка, необходимо контролировать гемоглобин.
Также малокровие возможно и некоторое время после родов.
Продолжительные болезни. Недостаточность почек, язвы желудка, кишечника, патологии печени приводят к постоянным потерям крови организмом женщины.
Донорство. Регулярная сдача крови на донорство, также может провоцировать анемию. В это время необходимо усиленно питаться, для замещения потерянной организмом крови.
Малое количество употребляемых витаминов В12 и фолиевой кислоты. При вегетарианстве и отказе от животной пищи, неправильных диетах, происходит дефицит таких важных организму витаминов.
Факт! Основными факторами, провоцирующими недостаток железа в организме, являются патологии желудочного тракта и неправильный рацион питания. До 60 % представительниц женского пола, страдает от анемии при постоянном соблюдении диеты.
Причины возникновения железодефицитной анемии
Причины развития железодефицитной анемии могут заключаться в нехватке железа, поступающего в организм извне, или в сбоях потребляющих его процессов, ведь самостоятельно организм человека не может вырабатывать этот микроэлемент. Ими могут стать:
- несбалансированное питание: не грамотно подобранная диета, отказ от употребления мяса (вегетарианство);
- регулярные значительные кровопотери. Помимо менструаций у женщин хронические потери крови могут быть связаны с наличием различных заболеваний: язва желудка, геморрой, распадающиеся опухоли и другие. Также сюда можно отнести донорство крови, которое происходит чаще, чем 3-4 раза за один год;
- врожденные факторы, возникшие при внутриутробном развитии: наличие ЖДА у матери, многоплодная беременность, недоношенность;
- сбои в работе желудочно-кишечного тракта, в результате которых нарушается процесс всасывания железа в двенадцатиперстной кишке. Это может быть связано с наличием различных заболеваний кишечника (энтерит, гастрит, целиакия, рак желудка, болезнь Крона и т.д.);
- болезни печени, приводящие к нарушениям в выработке трансферрина – белка, осуществляющего транспортные функции: поступающие с пищей микроэлементы не распределяются по организму, из-за чего возникает дефицит железа. Синтез трансферрина происходит в клетках печени;
- прием лекарственных препаратов, оказывающих влияние на всасывание и переработку железа в превышенных дозах. Среди них могут быть: нестероидные противовоспалительные препараты, антациды, железосвязывающие препараты. Людям, имеющим предрасположенность к железодефицитной анемии, перед применением этих видов лекарств необходимо проконсультироваться с врачом.
Железодефицитная анемия у детей может развиваться в результате различных патологий при беременности, раннему переходу на искусственное кормление, ускоренным темпом роста (в случае недоношенности плода).
Провоцирующие факторы ЖДА
Усиленная потребность организма в железе и является главным провоцирующим фактором для развития железодефицитной анемии. Она может быть связана с такими жизненными процессами, как:
- беременность. При беременности женщине для нормального развития плода необходимо почти в два раза больше железа, чем в обычной жизни;
- грудное вскармливание. Как и в период беременности, во время кормления ребенка женский организм расходует гораздо больше железа, чем может получить.
Особенности лечения
Лечение анемии у женщин проводится после исключения другой патологии (лейкоза, врожденных аномалий, гемофилии). Комплексная терапия включает:
- Устранение причины малокровия. Могут понадобиться лечение имеющихся воспалительных заболеваний, отказ от курения и спиртных напитков, исключение контакта с химикатами, лечение гельминтозов.
- Прием медикаментов. Лечить железодефицитную анемию нужно препаратами железа и комплексными средствами с витаминами и микроэлементами. Применяются Ферро-Фольгамма, Сорбифер Дурулес, Феррум Лек, Ферлатум, Актиферрин и Мальтофер. При B12 и фолиеводефицитной анемиях назначаются Фолиевая кислота и Цианокобаламин. Часто применяются такие препараты, как Мамифол, Фолацин. При апластической анемии эффективны Эпостим и Эритростим. При анемии аутоиммунной этиологии применяются кортикостероиды и иммунодепрессанты.
- Строгую диету. Больным женщинам нужно отказаться от продуктов питания, затрудняющих всасывание и усвоение железа (черного чая, сои, риса, молока). Нужно чаще есть продукты, богатые фолиевой кислотой, железом, витамином C и кобаламинами. Полезны красное мясо, печень, овощи, фрукты, дрожжи, яйца и зелень. Необходимо максимально разнообразить рацион. Это обеспечит поступление в организм нужных веществ.
- Ведение здорового образа жизни.
- Переливание эритроцитов. Требуется при сильной кровопотере и низком уровне гемоглобина.
- Введение инфузионных средств (гипертонических растворов, электролитов, раствора глюкозы с аскорбиновой кислотой). Эффективно при острой постгеморрагической анемии у женщин.
- Коррекцию работы сердца, почек и печени. С этой целью назначаются симптоматические средства.
- Удаление селезенки (спленэктомию). Эта операция максимально эффективна при гемолитической анемии с микросфероцитозом.
- Форсированный диурез. Требуется при анемии токсической природы.
Важная информация: Как лечить анемию Минковского-Шоффара (наследственного сфероцитоза) у детей
Стадии развития ЖДА
Патогенез этой разновидности анемии выражается двумя основными периодами:
- Латентный (скрытый) период характеризуется уменьшением запасов железа в организме, в результате чего, падает уровень ферритина. При этом другие лабораторные показатели в анализе крови могут оставаться в пределах нормы. Организм старается компенсировать недостаток микроэлемента более активным всасыванием в кишечнике и выработкой транспортного белка. За счет этого, ЖДА на данном этапе еще не наступает, хотя предпосылки для нее уже присутствуют.
- Непосредственная железодефицитная анемия наступает в тот момент, когда уровень эритроцитов снижается настолько, что они уже не могут в достаточной мере обеспечивать свои функции. На этой стадии начинают более явственно проявляться основные симптомы и характерные черты заболевания.
Стадии и степени
Железодефицитная анемия у женщин (симптомы позволяют определить нарушения на раннем этапе развития заболевания) по мере прогрессирования патологических процессов постепенно проходит несколько стадии:
| Название | Описание |
| 1 стадия (прелатентная) | Расход железа по сравнению с его поступлением в организм человека больше, но его запасов хватает на нормальное функционирование многих систем. Для восстановления уровня железа достаточно правильно скорректировать питание, добавить в рацион БАДы. |
| 2 стадия (латентная) | Запасы железа постепенно уменьшаются, но уровень гемоглобина в норме. Появляются специфические признаки нарушений. Исследование покажет снижение ферритина и трансферрина. Латентная железодефицитная анемия у женщин требует правильного питания, применение биологически активных добавок (БАДы). В некоторых ситуациях пациентам прописывают лекарственные препараты с железом. |
| 3 стадия | Патологические процессы постепенно прогрессируют, а уровень эритроцитов остается в норме. |
| 4 стадия | Развивается микроцитарная гипохромная анемия. |
| 5 стадия | Недостаток железа приводит к нарушению обменных процессов в тканях. Появляются первые серьезные симптомы железодефицитной анемии. |
Важно установить основную причину нехватки железа в организме человека. В большинстве случаев – это кровотечение. Анемия также может быть следствием серьезного заболевания. Необходимо диагностировать патологические процессы и начать лечение под наблюдением специалиста.
Учитывая количество гемоглобина в крови, различают следующие степени развития железодефицитной анемии:
| Название | Описание |
| Отсутствие анемии | Уровень гемоглобина выше 120 г/л. |
| I степень | Показатели снижаются до 90-120 г/л. Требуется консультация гематолога и корректирующая терапия. |
| II степень | Уровень гемоглобина колеблется в пределах 60-90 г/л. Женщине требуется срочная терапия. |
| III степень | Гемоглобин ниже 60 г/л. Пациентке показана госпитализация и интенсивное лечение. |
Определить стадию и степень развития патологического состояния поможет анализ крови. В некоторых ситуациях врач назначает дополнительные лабораторные тесты.
Виды железодефицитной анемии
Классификация заболевания по причинам возникновения выделяет следующие виды:
- анемия, возникшая в результате обильной потери крови;
- железодефицитная анемия, появившаяся как следствие сбоев в работе эритроцитов;
- хроническая железодефицитная анемия;
- гемолитическая анемия (возвышает при высокой степени разрушения эритроцитов).
Классификация по уровню гемоглобина разделяет заболевание на виды в зависимости от тяжести:
- легкая степень тяжести (содержание гемоглобина более 90 г/л);
- средняя степень тяжести (70-90 г/л);
- высокая степень тяжести (ниже 70 г/л).
Какие последствия анемии и в чем ее опасность?
Чтобы не допустить прогрессирование анемии, с развитием осложнений, следует консультироваться у квалифицированного врача, который назначит эффективную терапию.
Низкие уровни гемоглобина опасны для организма женщины, потому что приводят к гипоксии (недостатку кислорода в тканях и органах, в том числе и жизненно важных).
Игнорирование признаков анемии может привести к следующим последствиям:
- Отклонения работы органов. Малое количество кислорода значительно сказывается на работе внутренних органов и тканей. При недостатке его, происходит различного вида отклонения, в том числе и серьезные,
- Расстройства нервной системы. Возможны нарушения в режиме сна, уменьшение интеллектуальных способностей, эмоциональная неустойчивость, вспыльчивость, агрессивность,
- Сбои в работе сердечной системы. Сердце начинает работать с большей силой, при недостатке красных телец в организме, дабы компенсировать их. В следствии этого оно быстро изнашивается и остановки сердца при анемии являются часто регистрируемым фактором,
- Упадок иммунной системы. Слабый иммунитет приводит к быстрой заболеваемости инфекциями. Возрастает шанс прогрессирования заболеваний, связанных с низким иммунитетом.
Симптомы железодефицитной анемии
Степень ЖДА усиливается в организме постепенно и поначалу может практически не давать о себе знать. Латентный период заболевания характеризуется проявлением сидеропенического синдрома.
Позднее начинает проявляться общеанемический синдром, явственность которого определяется тяжестью анемии и способностью организма к сопротивлению. Наличие у пациента следующих признаков может свидетельствовать о заболевании железодефицитной анемией:
- быстрая утомляемость и хроническая усталость мышц. При дефиците железа в организме мышцы человека становятся более слабыми. На их повседневную работу затрачивается много энергии, которая перестает вырабатываться в нужном количестве из-за снижения уровня эритроцитов. В результате человек гораздо быстрее утомляется даже при небольших повседневных нагрузках. Железодефицитная анемия у детей может проявиться в стремлении ребенка к менее активным играм, вялом поведении и сонливости;
- появление одышки. При ЖДА затрудняется снабжение сердца кислородом из-за ухудшения циркуляции крови. По этой причине у пациента может наблюдаться учащение сердцебиения, появляется одышка и нехватка воздуха;
- ухудшение состояния кожи, ногтей и волос. Недостаток железа становится заметным внешне (см фото выше), когда кожные покровы становятся сухими и покрываются трещинами, появляется бледность. Ногти ослабевают, ломаются и покрываются специфичными поперечными трещинами. В некоторых случаях может наблюдаться выгибание ногтевой пластины в обратную сторону. Волосяной покров редеет. Волосы меняют свою структуру, раньше срока проявляется седина;
- поражение слизистых оболочек. Одним из ранних симптомов ЖДА является поражение слизистых покровов, потому как эти ткани наиболее остро ощущают недостаток железа из-за нарушения различных клеточных процессов: наиболее ярко поражение слизистых оболочек заметно в изменениях внешнего вида языка. Он становится гладким, покрытым трещинами и участками покраснений. Добавляются болевые ощущения, жжение. В некоторых случаях наблюдаются резкие нарушения во вкусовом восприятии;
- в полости рта появляется сухость и области атрофии. Появляется дискомфорт при употреблении пищи и боль при проглатывании. На губах образуются трещины;
- атрофия слизистой оболочки кишечника, вызванная железодефицитной анемией, сопровождается появлением болевых синдромов в животе, запорами, диареей. Ухудшается способность желудочно-кишечного тракта к всасыванию полезных веществ;
- поражение слизистых покровов мочеполовой системы характеризуется болями при мочеиспускании и недержанием мочи (как правило, в детском возрасте). Повышается риск заражения различными инфекциями;
Симптомы
Малокровие проявляется внешне (изменением цвета кожи, трофическими расстройствами, поражением слизистых) и внутренними признаками (дисфункцией органов). В ходе лабораторных анализов (диагностики) определяются следующие проявления анемии:
- Падение эритроцитов и гемоглобина в крови.
- Изменение концентрации сывороточного железа. Она снижается при талассемии, железодефицитном и хроническом постгеморрагическом малокровии. Повышение железа указывает на B12-дефицитную и гемолитическую формы данной патологии.
- Изменение цветового показателя (степени насыщения красных кровяных телец гемоглобином). Этот показатель повышен при B12 и фолиеводефицитном малокровии. Гипохромия характерна для талассемии, железодефицитной и хронической постгеморрагической анемий. При гемолитических и острых постгеморрагических формах малокровия цветовой показатель в норме.
- Изменение формы и размера эритроцитов.
- Снижение тромбоцитов и лейкоцитов. Наблюдается при гипопластической форме малокровия у женщин.
- Изменение состава костного мозга.
- Низкое содержание в крови кобаламина и фолиевой кислоты.
- Повышение билирубина. Характерно для гемолитической анемии.
Анемия у женщин характеризуется широкой вариабельностью клинических симптомов.
Внутренние симптомы
Ко внутренним (не выявляемым в процессе осмотра) симптомам анемии у женщин относятся:
- Нарушение обоняния и вкусовой чувствительности. Наблюдается при недостатке в организме железа.
- Мышечная слабость. Причиной является недостаточное поступление к мышцам кислорода.
- Быстрая утомляемость при физической работе.
- Респираторные расстройства в виде одышки и ощущения тяжести в груди.
- Головная боль и головокружение.
- Признаки нарушения функций желудочно-кишечного тракта (вздутие, диарея, запор, боль в животе, отсутствие аппетита).
- Увеличение печени и селезенки. Выявляется в ходе пальпации и перкуссии.
- Снижение памяти, ухудшение мышления и памяти.
- Сердечно-сосудистые расстройства (тахикардия, падение давления, боль в груди, чувство сердцебиения и замирания сердца).
- Обмороки.
- Снижение веса. Характерно для B12-дефицитного малокровия.
- Наличие мушек или тумана перед глазами. При анемии у женщин возможно снижение зрения.
- Чувствительные расстройства (мурашки, жжение, покалывание, ощущение тепла или холода). Наблюдается при малокровии на фоне нехватки кобаламинов.
- Двигательные расстройства (несогласованность движений, неуклюжесть).
- Нарушение мочеиспускания и дефекации.
- Ухудшение сна.
- Снижение работоспособности.
- Мигрень. Проявляется на фоне длительной кислородной недостаточности мозга.
Важная информация: Симптомы развития анемии Фанкони
Внешние признаки
Внешними признаками анемии у взрослых женщин являются:
- Изменение цвета кожи. Лицо становится бледным. Возможен легкий желтушный оттенок (при гемолитической анемии). Наиболее постоянный внешний признак малокровия у женщин.
- Бледность слизистой. Данный признак выявляется при осмотре слизистой рта.
- Сухость кожи, снижение ее эластичности, шелушение и наличие трещин.
- Потеря волосами блеска, их усиленное выпадение и истончение.
- Наличие трещин на губах и заед в уголках рта.
- Видимое глазом разрушение эмали зубов.
- Изменение ногтей на руках и ногах.
- Изменение языка (исчезновение сосочков, окрашивание в красный цвет, наличие трещин).
- Изменение цвета мочи. При гемолитической анемии она становится темно-коричневого или вишневого цвета.
- Изменение поведения.
- Наличие язв на коже рук и ног. Характерно для талассемии.
- Припухлость суставов и мышц.
- Изменение формы костей различных участков тела. Наблюдается при талассемии.
Диагностика ЖДА
Железодефицитная анемия у детей и взрослых может быть установлена любым специалистом, однако детальная диагностика, направленная на выявление причин, и лечение данного заболевания должны проводиться врачом-гематологом. Обследования пациента включают в себя:
- визуальный осмотр пациента – первый этап диагностики ЖДА. Специалисту необходимо со слов пациента определить общую картину развития патологии и провести осмотр, который поможет сделать выводы о степени заболевания и выявить осложнения, если они присутствуют;
- общий анализ крови из пальца или из вены – обобщенная картина здоровья пациента, с помощью которой врач может однозначно установить наличие или отсутствие ЖДА у больного. Данный анализ проводится в лаборатории с использованием специального оборудования – гематологического анализатора. Диагноз железодефицитная анемия устанавливается у пациента, в случае: уменьшения количества эритроцитов (у мужчин – менее 4,0 х 1012/л, у женщин – менее 3,5 х 1012/л), когда количество тромбоцитов и лейкоцитов в норме или увеличено;
- преобладания в крови пациента эритроцитов, у которых величина меньше нормальной (отклонением считается размер менее 70 мкм3);
- цветовой показатель (ЦП) меньше 0,8;
- сывороточное железо (СЖ): у мужчин – менее 17,9 мкмоль/л, у женщин – менее 14,3 мкмоль/л;
Железодефицитная анемия у детей характеризуется следующими результатами анализа крови:
- сывороточное железо (СЖ) ниже 14 мкмоль/л;
- общая железосвязывающая способность сыворотки (ОЖСС) более 63 мкмоль/л;
- ферритин в крови ниже 12 нг/мл;
- уровень гемоглобина (менее 110 г/л).
- пункция костного мозга – метод диагностики, базирующийся на заборе образцов костного мозга путем его забора специальным инструментом из грудинной кости. При заболевании ЖДА наблюдается рост эритроидного ростка кроветворения;
- рентгенография проводится с целью определения патологий кишечника, которые могут вызывать хронические кровотечения, тем самым становясь причиной развития анемии;
- эндоскопические исследования слизистых покровов человека также проводятся для выявления различных патологий органов брюшной полости. Это могут быть: фиброэзофагогастродуоденоскопия (ФЭГДС);
- ректороманоскопия;
- колоноскопия;
- лапароскопия и другие.
Анемия и ее разновидности
Эритроциты – красные кровяные тельца – имеют в составе белок гемоглобин, одной из функций которого является транспортировка кислорода к органам и тканям.
Когда синтез эритроцитов нарушается или организм теряет много крови, уровень гемоглобина падает. Развивается анемия, которую еще называют малокровием. Она не является самостоятельной патологией, а диагностируется как результат деструктивных процессов в системе кроветворения.
Это состояние может возникать как у взрослых, так и у детей. Чаще всего от него страдают взрослые женщины.
Классифицируют 6 основных видов анемии:
- Гипопластическую. Она развивается из-за разрушительных изменений в костном мозге. Клетки погибают, и это неизбежно отражается на функции кровообразования.
- Гемолитическую. Данная разновидность обусловлена проблемами с синтезом эритроцитов: количества воспроизводимых клеток не хватает, чтобы покрыть дефицит от естественной их гибели. В результате формируется недостаточность, и развивается малокровие.
- Постгеморрагическую. Возникает по причине дисбаланса компонентов крови или ее нехватки в связи со значительной кровопотерей. Такая форма анемии – последствие травм и ранений. Она развивается стремительно и требует неотложных мер.
- Дефицитную. Эта форма, в свою очередь, может быть:
- железодефицитной;
- фолиеводефицитной;
- обусловленной нехваткой витамина В12.
Уже из названия понятно, что такое малокровие связано с нехваткой микроэлементов в организме.
Все виды анемии представляют опасность для здоровья, а порой и жизни.
Источник: https://ru.wikipedia.org/wiki/Анемия
Лечение железодефицитной анемии
По мнению врачей при лечении железодефицитной анемии у взрослых и детей нельзя ограничиваться только медикаментами. Восполнять дефицит важного микроэлемента лучше и проще всего при помощи здоровой пищи и правильно подобранной диеты.
Ежедневная норма железа, которую должен содержать рацион – не менее 20 мг. Следует отметить, что лечение этого заболевания будет неэффективным, если не принять мер по устранению первичной патологии, вызвавшей дефицит железа.
Для профилактики болезни каждому человеку следует каждый год проводить лабораторный анализ показателей крови, комплексно питаться и, при необходимости, вовремя устранять возможные причины значительной кровопотери.
Людям, имеющим предрасположенность к дефициту железа, следует обратиться к врачу за назначением курса лекарственных препаратов с высоким содержанием железа.
Питание и добавки
Сбалансированный рацион играет основную роль в профилактике и лечении ЖДА. При составлении диеты следует учитывать, что железо качественнее усваивается, если его прием осуществляется в совокупности с витамином C.
При этом этот микроэлемент лучше всего всасывается кишечником, если он содержится в продуктах животного происхождения (до 3 раз больше по сравнению с растительными продуктами).
Рейтинг продуктов, которые являются лидерами по количеству содержания железа, которые обязательно должны быть включены в лечебно-профилактическую диету при железодефицитной анемии:
- белая фасоль (72 мг);
- орехи всех видов (51 мг);
- гречневая крупа (31 мг);
- свиная печень (28 мг);
- патока (20 мг);
- пивные дрожжи (18 мг);
- морская капуста и водоросли (16 мг);
- семена тыквы (15 мг);
- чечевица (12 мг);
- ягоды черники (9 мг);
- говяжья печень (9 мг);
- сердце (6 мг);
- язык говяжий (5 мг);
- курага (4 мг).
Методы лечения
Железодефицитная анемия у женщин (симптомы требуют вмешательства терапевта или гематолога) возникает на фоне многочисленных факторов. Важно своевременно диагностировать патологические изменения.
Основная цель терапии – это устранить причину железодефицитной анемии у женщины. Необходимо также восполнить недостаток железа в ее организме и предупредить развитие дистрофических процессов. Важно сохранить целостность внутренних органов и правильное функционирование систем.
Лекарственные препараты
Медикаменты назначает врач, учитывая степень тяжести патологического состояния, индивидуальные особенности женского организма. Важно соблюдать строго предписания специалиста, поскольку многие препараты вызывают побочные эффекты.
Для восстановления уровня гемоглобина и железа назначаются следующие лекарства:
| Название | Применение | Противопоказания |
| «Тотема» | Содержимое 1 ампулы растворяют в 0,5 ст. воды. Для вкуса разрешается добавлять небольшое количество сахара. Суточная дозировка составляет 2-4 ампулы. |
|
| «Гемофер» | Рекомендуемая дозировка составляет 55 кап. 2 р. в сутки. Курс терапии продолжается 8 недель. |
|
| «Мальтофер» | Взрослая суточная дозировка составляет 100-300 мг. |
|
Аскорбиновая кислота и фруктоза улучшают всасывание железа. Лекарства рекомендуется принимать во время еды, чтобы действующие компоненты лучше всасывались. Курс терапии в большинстве случаев продолжается от 3-х до 5 месяцев, у каждого пациента все индивидуально. Среди частых побочных эффектов выделяют тошноту, запоры, болевые ощущения в области живота.
Народные методы
Повысить уровень гемоглобина помогают рецепты знахарей и целителей. Но перед их использованием следует проконсультироваться с врачом, чтобы предупредить возможные осложнения.
Многие компоненты могут спровоцировать аллергическую реакцию.
| Название | Рецепт | Применение |
| Настойка на чесноке | Продукт очистить и 300 г залить спиртом (1 л). Настаивать смесь 3 недели при комнатной температуре. | Полученную настойку принимают по 1 ч.л. 3 р. в сутки. Лекарство повышает уровень гемоглобина, очищает сосуды и оздоравливает весь организм. |
| Крапива | Для приготовления настойки понадобится 2 ст.л. сухой травы. Залить крапиву кипятком (1 ст.). Настоять 15 мин и процедить. | Трава не только повышает уровень гемоглобина, но и увеличивает количество эритроцитов. Крапива также оказывает антиоксидантное действие, выводя из организма вредные вещества. Настойку рекомендуется готовить каждый день свежую. Пить ее на протяжении дня небольшими глотками. |
| Травяной сбор | Смешать зверобой, корень солодки, листья земляники, побеги черники и тысячелистник в одинаковых пропорциях. Залить 7 г травяного сбора горячей водой (250 мл), поставить на водяную баню. Греть 10 мин. Настоять 2 ч. в закрытой емкости и хорошо процедить. | Полученное средство принимают в теплом виде по 1/3 ст. 3 р. в сутки перед едой за 20 мин. |
Обычная тыква содержит железо. Достаточно каждый день употреблять по 100-200 г вареного продукта, чтобы нормализовать состав крови.
Терапевт также рекомендует вместо чая пить отвар шиповника 3-4 р. в сутки. Основной компонент можно смешивать с плодами рябины, смородины, листьями малины или земляники.
Прочие методы
Железодефицитная анемия у женщин (симптомы патологических изменений помогут своевременно обратиться в больницу и пройти полное медицинское обследование) лечится комплексно под строгим наблюдением терапевта или гематолога.
Недостаток железа и низкий уровень гемоглобина, эритроцитов исправляют не только лекарственными препаратами. Диетическое питание позволит пополнить запасы железа. Биологически активные добавки (БАДы) также рекомендуется применять для улучшения процесса транспортировки и усвоения микроэлементов.
Правильное питание не избавит от железодефицитной анемии, но поможет повысить уровень железа. Зеленые овощи, салат и зелень содержат фолиевую кислоту. То же самое касается зерновых завтраков.
А вот кофеин мешает всасыванию железа.
| Рекомендуемые продукты | Запрещенные продукты |
|
|
При железодефицитной анемии не обязательно усиленно питаться, согласно установленным правилам. Достаточно включить в рацион продукты, которые содержат большое количество железа и фолиевой кислоты.
В случае, когда присутствует угроза жизни человека, ему делают переливание крови (трансфузия). Когда не помогает медикаментозное лечение, присутствуют тяжелые признаки железодефицитной анемии.
Прогноз и осложнения
Степень сложности такого заболевания, как железодефицитная анемия на сегодняшний день является достаточно низкой.
При своевременном обнаружении симптомов и проведении качественно диагностики этот недуг может быть полностью устранен без каких-либо последствий.
В некоторых случаях развитие осложнений при лечении ЖДА может произойти. Причинами для этого могут послужить следующие факторы:
- неграмотное проведение диагностических процедур и, как следствие, установление ложного диагноза;
- не выявление первой причин;
- несвоевременное принятие мер по лечению;
- неправильная дозировка назначенных лекарств;
- несоблюдение регулярности лечения.
Возможные осложнения данного заболевания это:
- у детей – задержки роста и интеллектуального развития. Детский дефицит железа является очень опасным, так как в запущенных случаях заболевания сбои в организме ребенка могут стать необратимыми;
- анемическая кома, которая развивается на фоне некачественной циркуляции кислорода в организме, в частности, из-за недостаточного обеспечения кислородом мозга. Характерные признаки этого осложнения – обморочные состояния, ослабленные и замеленные рефлексы. При неоказании своевременной квалифицированной помощи врачей создается сильная угроза для жизни больного;
- появление сердечной недостаточности – частое явление при долгой нехватке железа в организме;
- инфекционные заболевания при анемии могут стать причиной для развития сепсиса.
Данные виды осложнений представляют наибольшую угрозу для пациентов детского и преклонного возраста.
Причины анемии
Состояние недостаточного количества гемоглобина может сопровождать множество патологий, каждая из которых имеет свои причины и усугубляющие факторы. Но можно выделить ряд общих причин анемии, которые вызывают нарушения в организме у женщины:
- наследственность;
- нарушения питания;
- повышенные психические и физические нагрузки;
- некоторые состояния, сопровождающиеся с повышенной потребностью в питании клеток организма;
- негативные факторы окружающей среды, экология;
- хронические заболевания и их обострения;
- перенесённые инфекционные болезни.
У женщин после 40 лет анемия может быть вызвана гормональной перестройкой, замедлением метаболизма, а также развитием онкологических заболеваний. В этот период стоит быть особенно внимательной к своему здоровью и не допускать запущенности имеющихся хронических недугов.
В зависимости от серьёзности и характера причин анемии у взрослых женщин будут различаться проявления симптомов и методика лечения. К патологическому состоянию могут привести как погрешности в образе жизни и питании, так и опасные болезни. Поэтому при появлении первых подозрительных признаков необходимо обращаться к врачу.
Добавьте в рацион продукты, богатые витамином В12 и железом
Витамин В12 содержится в мясе (преимущественно, красном), печени, рыбе и морепродуктах (много его в устрицах). Есть и растительные источники витамина В12: тофу, чечевица, изюм, овсяная крупа и зерновые хлопья, но риск развития анемии у вегетарианцев всё равно достаточно высок. Однако выход есть — витамин В12 можно принимать в форме пищевых добавок, например, в составе витаминного комплекса.
Хорошие источники железа: тёмно-зеленые листья (шпинат, цветная и брюссельская капуста, брокколи). Лидеры по содержанию железа — петрушка и артишоки. Сладкие источники — курага и чернослив.
Причины возникновения скрытого дефицита железа
Недостаток вызывается разными причинами.
Таблица – Причины возникновения скрытого дефицита железа
| Причина | Механизм проявления |
| Питание | Вегетарианство, диета, для похудения обедненная продуктами с железом вызывает истощение его запасов. В организме железо, не вырабатывается и источником данного микроэлемента, являются продукты питания. |
| Несовместимость продуктов | Продукты питания оказывают влияние на усвояемость микроэлементов и витаминов, содержащихся в продуктах. Кофе, чай содержат танин, который препятствует усвоению железа. Ca и Fe не сочетаются так как нейтрализуют друг друга (греча с молоком). |
| Нарушение усвояемости | Нарушение нормальной микрофлоры, обеднение 12-кишки при заболеваниях инфекционных и как последствие антибиотикотерапии нарушают усвояемость. Слизистая становится уязвимой и не воспринимает некоторые элементы. |
| Рост и развитие | В период роста организм ребенка использует витамины и вещества более быстро и возникает их недостаток в организме. Полноценное питание восполняет недостаток, но и его может быть недостаточно. |
| Период вынашивания плода | Железо является необходимым компонентом, который обеспечивает построение плаценты, усиленный метаболизм, развитие плода и его потребности. Всего потребность организма составляет 1200–1140 мг., которые составляют до 6 мг в сутки. |
| Физический труд | Железо имеет свойство выводиться при потоотделении при физической работе, занятиях спортом. |
| Кровотечения | Носовые кровотечения, донорство, заболевания ЖКТ сопровождающиеся кровотечениями приводят к снижению железа в организме. Риск снижения его особенно характерен при обильных менструациях женщин в репродуктивном возрасте. |
Гемоглобин снижается при гинекологических заболеваниях (миоме, эндометриозе) и иногда при внутриматочной контрацепции.
Хирургические вмешательства не всегда становятся причиной снижения гемоглобина в организме. При кровопотерях в результате операций и других причинах. В группе риска находятся новорожденные дети, так как до 2 лет в организме ребенка присутствует материнское железо.
Функции железа в организме человека
Роль железа в организме человека разнообразна. Железо участвует в процессах:
- кроветворения;
- обеспечения поступления кислорода и дыхания клеток;
- окислительно-восстановительные реакции внутри клеток;
- иммунологические.
Входит в состав белков, ферментов, цитохромов. Физиологические функции его обеспечивают нормальное функционирование щитовидной железы. Оно является детоксикационным веществом участвующее в сложной цепи превращений билирубина. Обезвреживая токсины, скапливающиеся в печеночной ткани, защищает ткани от образующейся перекиси водорода. Она образуется лейкоцитами для нейтрализации ферментов патогенных микроорганизмов.
Депо железа – селезенка, печень, костный мозг. Суточная норма его – 10–30 мг, которая для детей составляет до 18 лет – 5–15 мг и, увеличивается с возрастом. Мужчина должен получать 10 мг, а женщина – 15 мг., но в период беременности и грудного вскармливания до 20 мг.
Микроэлемент участвует в усвояемости витаминов группы В и его нехватка влияет на состояние кожи, волос, ногтей (сухость, ломкость).